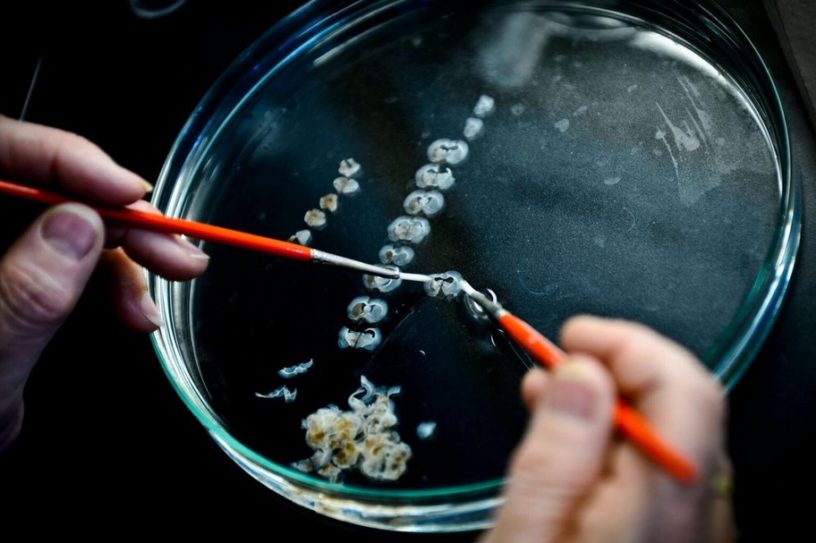
cerveau rat maladie parkinson traitement genie genetique cellules souches

Le thylacine (Thylacinus cynocephalus), aussi appelé loup (ou tigre) de Tasmanie, était un mammifère marsupial au pelage tigré. Largement répandu...
génie génétique
Des chercheurs ont réalisé une avancée spectaculaire dans le domaine du génie génétique en concevant un organisme synthétique unicellulaire qui...
La lutte intérieure que vivent les humains tout en réalisant leur propre mortalité apparaît très tôt dans la vie, dès...
Généralement amateur de théories du complot en tout genre, le président Donald Trump n’a pas hésité à soutenir, au début...
Les voyages spatiaux et la colonisation spatiale en règle générale posent plusieurs problèmes d’ordre humain et technologique. L’un des problèmes...
Selon des experts, malgré les défis actuels, de nouveaux progrès dans le domaine de la biologie des cellules souches et...
Alors que le génie génétique avance à grands pas avec des outils d’édition tels que CRISPR-Cas9, dont la dernière version...
Dans le cadre d’une nouvelle étude prometteuse, des chercheurs de l’Université d’Arizona présentent un nouveau type de cellule T génétiquement...
Au cours des dernières années, le génie génétique a connu un essor considérable comme moyen de traitement de plusieurs pathologies...
Afin d’étudier le rôle d’un gène particulier dans les premières phases du développement humain, des chercheurs londoniens ont utilisé la...
Des médecins spécialistes des grands brûlés du Massachusetts General Hospital (MGH), ont annoncé avoir utilisé avec succès de la peau...